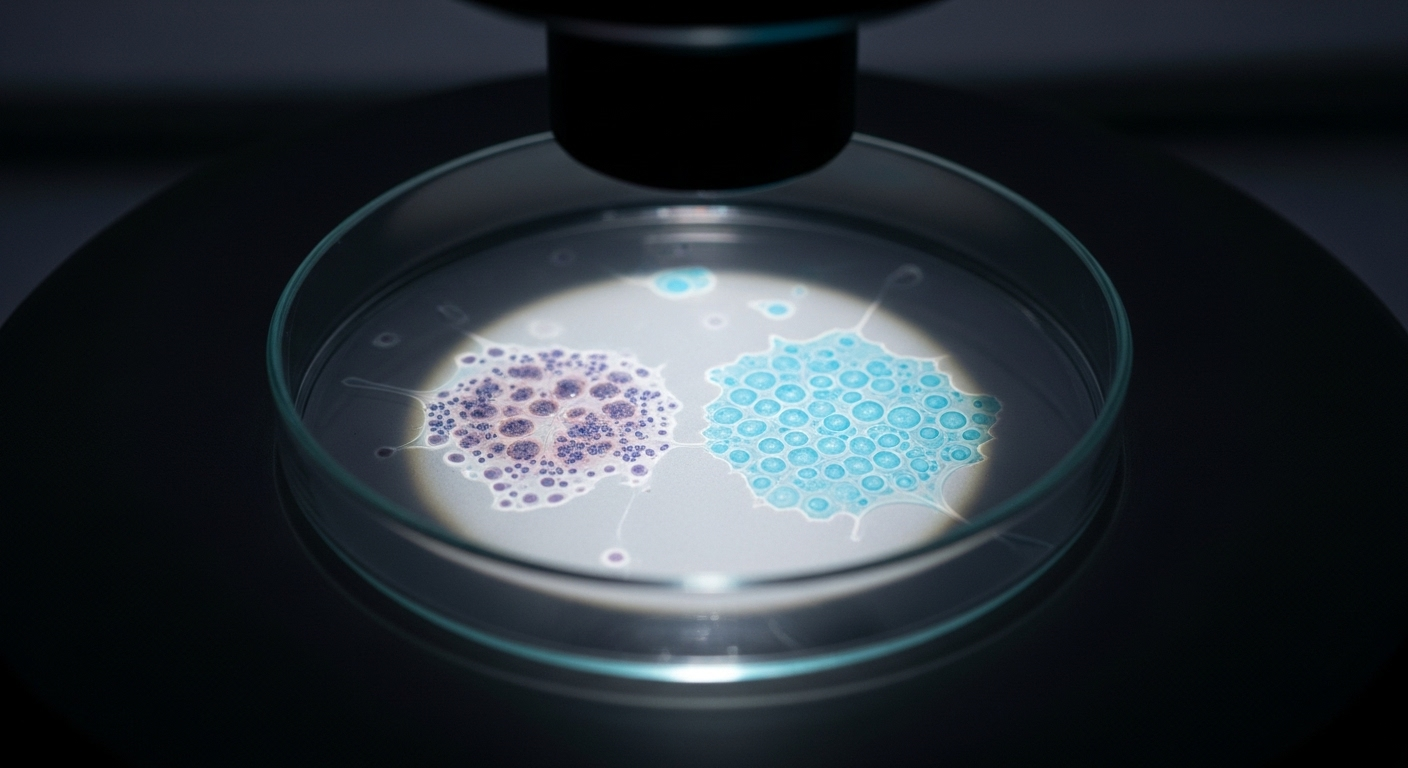
Des premiers tests qui donnent le sourire

On entend souvent parler de la lutte contre le cancer comme d’une guerre. Et dans cette guerre, les chercheurs viennent peut-être de trouver une nouvelle arme, une arme incroyablement maligne. Imaginez un traitement qui ne s’attaque pas à tout, comme une bombe, mais qui vise avec une précision d’horloger la source d’énergie des cellules malades pour les forcer à… s’éteindre d’elles-mêmes. C’est la promesse incroyable d’une équipe de chercheurs américains. Une avancée qui pourrait bien changer la donne pour des cancers aujourd’hui très difficiles à soigner.
Le problème : des cancers particulièrement têtus

Parlons d’abord du vrai problème. Il existe des cancers, comme ceux de la tête et du cou, qui sont de vrais durs à cuire. Les médecins utilisent bien sûr tout ce qu’ils peuvent : la chirurgie, la chimiothérapie, la radiothérapie. Mais même avec tout ça, il arrive trop souvent que la maladie revienne. Et puis, soyons honnêtes, ces traitements sont lourds. Ils sont un peu comme un marteau-piqueur qui détruit le mur malade, mais qui fissure aussi les murs sains tout autour. Les effets secondaires sont parfois terribles, parce que ces traitements puissants ne font pas toujours la différence entre les bonnes et les mauvaises cellules.
La découverte : le talon d'Achille des cellules cancéreuses

Et si ces cellules si agressives avaient une faiblesse secrète ? C’est exactement ce que les scientifiques ont trouvé. Elles manquent d’une chose bien précise : une sorte de graisse appelée le céramide. Dans une cellule normale, quand il y a un gros stress, ce céramide agit comme un signal d’alarme qui dit à la cellule : « il est temps de s’autodétruire pour protéger le reste du corps ». Mais voilà, ces cellules cancéreuses de la tête et du cou n’en ont presque pas. C’est ce qui leur permet de grandir, de se multiplier sans aucun contrôle. Franchement, c’est comme si elles avaient trouvé le moyen de couper leur propre système d’alarme.
L'arme secrète : un médicament intelligent nommé LCL768

Face à cette découverte, les chercheurs ont eu une idée de génie. Puisque les cellules malades manquent de céramide, pourquoi ne pas leur en donner ? Ils ont donc créé en laboratoire une version améliorée de cette substance, qu’ils ont appelée LCL768. Ce n’est pas n’importe quelle substance. Elle est conçue spécialement pour être capable de pénétrer à l’intérieur des cellules cancéreuses, un peu comme un cheval de Troie. Une fois dedans, elle ne reste pas à l’entrée : elle va se loger directement au cœur du réacteur, dans les petites usines à énergie de la cellule, que l’on appelle les mitochondries.
Comment ça marche ? la cellule forcée de couper son propre courant

Alors, une fois que le médicament LCL768 est dans la place, que se passe-t-il ? C’est là que ça devient fascinant. Il déclenche un processus que les scientifiques appellent la mitophagie. Pour faire simple, c’est comme si le médicament donnait l’ordre à la cellule de manger ses propres usines à énergie. La cellule, piégée, se met donc à détruire ses propres mitochondries. Privée de sa source d’énergie, elle ne peut plus fonctionner. Elle s’affaiblit et finit par mourir. C’est comme si on coupait le courant dans une usine : tout s’arrête.
Le coup de grâce : un double K.O. pour la tumeur

Et ce n’est pas tout. Le traitement ne se contente pas de saboter les usines à énergie, il coupe aussi l’arrivée de carburant ! En plus de déclencher l’autodestruction, le LCL768 bloque une autre substance essentielle à la cellule, le fumarate. C’est un peu le carburant qui fait tourner le moteur. Donc la cellule se retrouve face à un double problème : on lui ordonne de détruire son moteur et, en même temps, on coupe l’arrivée d’essence. Résultat ? C’est le K.O. technique. La cellule cancéreuse s’effondre complètement, incapable de survivre.
Des premiers tests qui donnent le sourire
Bien sûr, tout ça est très beau en théorie, mais est-ce que ça marche en pratique ? Les premières réponses sont un grand OUI. Les chercheurs ont testé le LCL768 sur des souris qui avaient des tumeurs, mais aussi directement sur des morceaux de tumeurs prélevés sur de vrais patients. Les résultats sont là : la croissance des tumeurs a été très nettement freinée. Et la meilleure nouvelle dans tout ça, c’est que le traitement semble très peu affecter les cellules saines. Pourquoi ? Parce que nos cellules saines ne sont pas aussi dépendantes de ce mécanisme pour survivre. C’est un traitement ciblé, précis. On peut donc espérer beaucoup moins d’effets secondaires. C’est une perspective formidable pour les malades.
Et maintenant, que peut-on espérer ?

Pour l’instant, il faut rester prudent : le médicament n’a pas encore été testé sur l’homme. C’est la prochaine grande étape. Les scientifiques doivent d’abord s’assurer qu’il est parfaitement sûr avant de le proposer à des patients. Mais l’espoir est immense. Ce manque de céramide a été observé dans d’autres types de cancers. Ce traitement pourrait donc, un jour, servir à soigner bien d’autres maladies. On parle ici d’une toute nouvelle façon de traiter le cancer, plus fine, plus intelligente, et peut-être plus douce pour le corps. C’est une porte qui s’ouvre sur des traitements vraiment personnalisés.
Conclusion : un grand pas pour la médecine et pour les patients

En résumé, cette avancée n’est pas juste une découverte de plus. C’est un véritable changement de stratégie. Au lieu d’utiliser une force brute qui abîme tout sur son passage, on utilise l’intelligence pour retourner la propre faiblesse du cancer contre lui. C’est une preuve que la recherche avance à pas de géant. Même s’il faudra encore du temps et de la patience, chaque découverte comme celle-ci est une lumière au bout du tunnel pour des milliers de patients et leurs familles. C’est une histoire de science, bien sûr, mais c’est avant tout une magnifique histoire d’espoir.
Selon la source : slate.fr